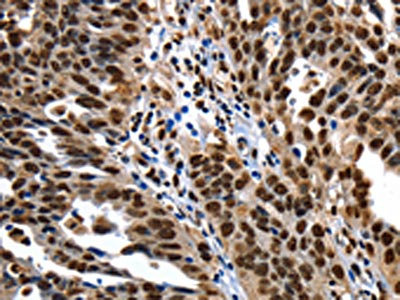

XRCC6 Antibody
-
中文名稱:XRCC6兔多克隆抗體
-
貨號:CSB-PA257066
-
規(guī)格:¥1100
-
圖片:
-
The image on the left is immunohistochemistry of paraffin-embedded Human colon cancer tissue using CSB-PA257066(XRCC6 Antibody) at dilution 1/10, on the right is treated with fusion protein. (Original magnification: ×200)
-
The image on the left is immunohistochemistry of paraffin-embedded Human ovarian cancer tissue using CSB-PA257066(XRCC6 Antibody) at dilution 1/10, on the right is treated with fusion protein. (Original magnification: ×200)
-
-
其他:
產(chǎn)品詳情
-
Uniprot No.:
-
基因名:
-
別名:5''-deoxyribose-5-phosphate lyase Ku70 antibody; 5''-dRP lyase Ku70 antibody; 70 kDa subunit of Ku antigen antibody; ATP dependent DNA helicase 2 subunit 1 antibody; ATP dependent DNA helicase II 70 kDa subunit antibody; ATP-dependent DNA helicase 2 subunit 1 antibody; ATP-dependent DNA helicase II 70 kDa subunit antibody; CTC box binding factor 75 kDa subunit antibody; CTC box-binding factor 75 kDa subunit antibody; CTC75 antibody; CTCBF antibody; DNA repair protein XRCC6 antibody; G22P1 antibody; Ku 70 antibody; Ku autoantigen p70 subunit antibody; Ku autoantigen, 70kDa antibody; Ku p70 antibody; Ku70 antibody; Ku70 DNA binding component of DNA-dependent proteinkinase complex (thyroid autoantigen 70 kDa antibody; Kup70 antibody; Lupus Ku autoantigen protein p70 antibody; ML8 antibody; Thyroid autoantigen 70kD (Ku antigen) antibody; Thyroid autoantigen antibody; Thyroid lupus autoantigen antibody; Thyroid lupus autoantigen p70 antibody; Thyroid-lupus autoantigen antibody; TLAA antibody; X ray repair complementing defective repair in Chinese hamster cells 6 antibody; X-ray repair complementing defective repair in Chinese hamster cells 6 antibody; X-ray repair cross-complementing protein 6 antibody; XRCC 6 antibody; Xrcc6 antibody; XRCC6_HUMAN antibody
-
宿主:Rabbit
-
反應種屬:Human,Mouse
-
免疫原:Fusion protein of Human XRCC6
-
免疫原種屬:Homo sapiens (Human)
-
標記方式:Non-conjugated
-
抗體亞型:IgG
-
純化方式:Antigen affinity purification
-
濃度:It differs from different batches. Please contact us to confirm it.
-
保存緩沖液:-20°C, pH7.4 PBS, 0.05% NaN3, 40% Glycerol
-
產(chǎn)品提供形式:Liquid
-
應用范圍:ELISA,IHC
-
推薦稀釋比:
Application Recommended Dilution ELISA 1:1000-1:5000 IHC 1:10-1:50 -
Protocols:
-
儲存條件:Upon receipt, store at -20°C or -80°C. Avoid repeated freeze.
-
貨期:Basically, we can dispatch the products out in 1-3 working days after receiving your orders. Delivery time maybe differs from different purchasing way or location, please kindly consult your local distributors for specific delivery time.
-
用途:For Research Use Only. Not for use in diagnostic or therapeutic procedures.
相關產(chǎn)品
靶點詳情
-
功能:Single-stranded DNA-dependent ATP-dependent helicase that plays a key role in DNA non-homologous end joining (NHEJ) by recruiting DNA-PK to DNA. Required for double-strand break repair and V(D)J recombination. Also has a role in chromosome translocation. Has a role in chromosome translocation. The DNA helicase II complex binds preferentially to fork-like ends of double-stranded DNA in a cell cycle-dependent manner. It works in the 3'-5' direction. During NHEJ, the XRCC5-XRRC6 dimer performs the recognition step: it recognizes and binds to the broken ends of the DNA and protects them from further resection. Binding to DNA may be mediated by XRCC6. The XRCC5-XRRC6 dimer acts as regulatory subunit of the DNA-dependent protein kinase complex DNA-PK by increasing the affinity of the catalytic subunit PRKDC to DNA by 100-fold. The XRCC5-XRRC6 dimer is probably involved in stabilizing broken DNA ends and bringing them together. The assembly of the DNA-PK complex to DNA ends is required for the NHEJ ligation step. Probably also acts as a 5'-deoxyribose-5-phosphate lyase (5'-dRP lyase), by catalyzing the beta-elimination of the 5' deoxyribose-5-phosphate at an abasic site near double-strand breaks. 5'-dRP lyase activity allows to 'clean' the termini of abasic sites, a class of nucleotide damage commonly associated with strand breaks, before such broken ends can be joined. The XRCC5-XRRC6 dimer together with APEX1 acts as a negative regulator of transcription. In association with NAA15, the XRCC5-XRRC6 dimer binds to the osteocalcin promoter and activates osteocalcin expression. Plays a role in the regulation of DNA virus-mediated innate immune response by assembling into the HDP-RNP complex, a complex that serves as a platform for IRF3 phosphorylation and subsequent innate immune response activation through the cGAS-STING pathway.
-
基因功能參考文獻:
- KU70 defect influenced the expression of P53, BCL2 and BAX, remaining Jurkat cells in a pro-apoptosis status and KU70 silencing prolonged the survival time and impaired the tumorigenesis ability in Jurkat-xenografted mice. PMID: 30273928
- Small cell lung cancer (SCLC) subtype had amplified risk with XRCC7 6721G>T. Gene-environment interaction analysis revealed that XRCC6 61C>G showed a strong protective effect towards lung cancer. Survival analysis revealed poor prognosis in case of XRCC6 61C>G SCLC subtype. XRCC7 6721G>T subjects with SCLC subtype showed an increased susceptibility while poor prognosis in case of XRCC6 61C>G. PMID: 29397516
- verexpression of USP50 has no effect on Ku70 mRNA levels, while it reduces Ku70 protein levels by promoting Ku70 degradation, suggesting that USP50 may indirectly regulate Ku70 protein stability. PMID: 29101126
- Observations suggest that IER5 is a novel regulator of the non-homologous end-joining pathway pathway for DNA double-strand breaks repair, possibly through its interaction with PARP1 and Ku70. PMID: 29104487
- The DNA binding domain of Ku70 was essential for formation of the Ku70-STING complex. Knocking down STING in primary human macrophages inhibited their ability to produce IFN-lambda1 in response to transfection with DNA or infection with the DNA virus HSV-2 (herpes simplex virus-2). Together, these data suggest that STING mediates the Ku70-mediated IFN-lambda1 innate immune response to exogenous DNA or DNA virus infection. PMID: 28720717
- analysis of a novel cellular stress response mechanism in cancer cells and a key role of LSD1/SIRT1/KU70 dynamic interaction in regulating DNA repair and mutation acquisition PMID: 27384990
- Single nucleotide polymorphisms in the Ku70 gene XRCC6 were independently associated with Elevated Creatine Kinase Levels in Unhealthy Male Nonagenarians. PMID: 26913518
- Although PAXX-deficient cells lack c-NHEJ phenotypes, PAXX forms a stable ternary complex with Ku bound to DNA. Thus, PAXX plays an accessory role during c-NHEJ that is largely overlapped by XLF's function. PMID: 27705800
- HTLV-1 infection enhanced the association between Ku70 and stimulator of IFN genes, suggesting that stimulator of IFN genes was involved in Ku70-mediated host defenses against HTLV-1 infection; findings suggest a new sensor that detects HTLV-1 reverse transcription intermediate and controls HTLV-1 replication PMID: 28821586
- Nuclear PTEN interferes with binding of Ku70 at double-strand breaks through post-translational poly(ADP-ribosyl)ation. PMID: 27741411
- Results show that DDB2 is critical for chromatin association of XRCC5/6 in the absence of DNA damage and provide evidence that XRCC5/6 are functional partners of DDB2 in its transcriptional stimulatory activity. PMID: 28035050
- High KU70 expression is associated with drug resistance in glioblastoma. PMID: 27593939
- These results suggest that Ku-mediated repression of p53 mRNA translation constitutes a novel mechanism linking DNA repair and mRNA translation. PMID: 26964895
- VCP removes sterically trapped Ku70/80 rings from DNA in double-strand break repair. PMID: 27716483
- found that the rs228593, rs2267437 and rs1805388 functional polymorphisms probably alter the level of expression of the ATM, XRCC6 and LIG4 genes, respectively, being important in the maintenance of genomic instability in MDS PMID: 27497341
- Data show that the increased acetylation of Ku autoantigen 70kDa (Ku70) in sirtuin 6 protein (SIRT6)-depleted cells disrupt its interaction with Bax apoptosis regulator protein (Bax), which finally resulted in Bax mitochondrial translocalization. PMID: 28238784
- Ku70 (XRCC6) was found to bind directly within the CR4 of E1A from human adenovirus type 5. PMID: 27769014
- periodic phosphorylation of Ku70 by cyclin-cyclin dependent kinases prevents the interaction of Ku with replication origin after initiation events in S-phase. PMID: 27402161
- The results of this preclinical study imply that Ku70 might be a primary resistance factor of gemcitabine, and Ku70 silence could significantly chemo-sensitize gemcitabine in pancreatic cancer cells. PMID: 28153717
- results reveal that Src plays a protective role against hyperactive apoptotic cell death by reducing apoptotic susceptibility through phosphorylation of Ku70 at Tyr-530. PMID: 27998981
- High Expression of XRCC6 Promotes Human Osteosarcoma Cell Proliferation through the beta-Catenin/Wnt Signaling Pathway. PMID: 27455247
- Data show that X-ray repair cross-complementing protein 6 ( Ku70) is found to interact with closed circular DNA. PMID: 27825805
- The rs2267437 in XRCC6 was associated with increased initial DSB damage. PMID: 26974709
- No significant difference in genotype distribution was found between the colorectal cancer patients and controls, or any significant association with cancer-specific or disease-free survival in patients. PMID: 27328741
- Ku70 expression may play an important role in hepatocellular carcinoma development PMID: 26797321
- Results show that under hypoxia, Ku70 and DNA-PKcs interact with nuclear RON which activates non-homologous end joining DNA repair conferring chemoresistance. PMID: 26772202
- We believe that for the first time, genetic variants at XRCC6 and MVP genes are associated with risk of more aggressive disease, and would be taken into account when assessing the malignancy of prostate cancer PMID: 26754263
- XRCC6 may play an important role in the carcinogenesis of NPC and could serve as a chemotherapeutic target for personalized medicine and therapy. PMID: 26149939
- these data unveil an involvement of phospho-Ku70 in fast but inaccurate DNA repair; a new paradigm linked to both the deregulation of canonical nonhomologous end-joining and the resistance of malignant cells PMID: 26337656
- Ku is intact and retains DNA binding activity in early apoptotic cells. PMID: 26976509
- Data suggest that heat shock factor 1 (HSF1) interacts with both Ku autoantigens Ku70 and Ku86 to induce defective non-homologous end joining (NHEJ) repair activity and genomic instability. PMID: 26359349
- Our results demonstrate that the phosphorylation-mediated dissociation of Ku70/80 from DSBs frees DNA ends, allowing the initiation of HR in S phase and providing a mechanism of DSB repair pathway choice in mammalian cells. PMID: 26712563
- retinoblastoma tumor suppressor protein variants disabled for the interaction with XRCC5 and XRCC6, including a cancer-associated variant, are unable to support canonical non-homologous end-joining despite being able to confer cell-cycle control PMID: 25818292
- the results of the present study suggested that Ku70 acetylation mediated TSA-induced apoptosis in CRC cells. In addition, Ku70 was found to be indispensable in TSA-induced apoptosis due to its role in protecting Bax from proteosomal degradation. PMID: 25695595
- A direct interaction between Ku70/86 and BRG1 brings together SWI/SNF remodeling capabilities and TOP2beta activity to enhance the transcriptional response to hormone stimulation. PMID: 26055322
- Ku70 is a novel Mcl-1 deubiquitinase that could be a potential target for cancer therapy by manipulating Mcl-1 deubiquitination. PMID: 24769731
- loss of expression correlates with decreased survival in gall bladder malignancies patients PMID: 25046228
- SMAR1-mediated regulation of repair and apoptosis via a complex crosstalk involving Ku70, HDAC6 and Bax. PMID: 25299772
- Polymorphism in XRCC6 gene is associated with Systemic Lupus Erythematosus. PMID: 25756210
- Both the CG carriers/G allele carriers of rs2267437 (XRCC6) and the haplotype AT/CC established by the SNPs of XRCC5 are associated with ESCC (Esophageal Squamous Cell Carcinoma) susceptibility. PMID: 25702660
- EEF1A1, SSRP1, and XRCC6 are novel interacting partners of the mineralocorticoid receptor PMID: 25000480
- single nucleotide polymorphisms in promoter region might play different roles in various cancers [review] PMID: 25569644
- RECQL4 stimulates higher order DNA binding of Ku70/Ku80 to a blunt end DNA substrate. Taken together, these results implicate that RECQL4 participates in the NHEJ pathway of DSB repair via a functional interaction with the Ku70/Ku80 complex. PMID: 24942867
- the VNTR polymorphism at the promoter region of XRCC5, but not XRCC6, may have a role in breast cancer risk or age at diagnosis of breast cancer PMID: 24615008
- SET/TAF-Ibeta interacts with Ku70/80 in the nucleus and inhibits Ku70 acetylation. PMID: 24305947
- A single nucleotide polymorphism that tags both the XRCC6 and SREBF2 genes strongly modifies the association between bladder cancer risk and smoking PMID: 24382701
- Enhanced DNA-PKcs and Ku 70/80 expression may be closely associated with gastric carcinoma. PMID: 24187467
- This meta-analysis suggests that the XRCC6 rs2267437 polymorphism may affect breast cancer susceptibility and increase the risk of cancer in Asian populations and in the general population. PMID: 23745766
- findings suggest that the XRCC6 genotype could serve as a predictor of childhood leukemia risk and XRCC6 could serve as a target for personalized medicine and therapy PMID: 24324074
- KU70/KU80 may play a role in DNA DSBs repair in HR-deficient tumours. Further study of other NHEJ markers in sporadic BC is warranted. PMID: 23624778
顯示更多
收起更多
-
亞細胞定位:Nucleus. Chromosome.
-
蛋白家族:Ku70 family
-
數(shù)據(jù)庫鏈接:
Most popular with customers
-
-
Phospho-YAP1 (S127) Recombinant Monoclonal Antibody
Applications: ELISA, WB, IHC
Species Reactivity: Human
-
-
-
-
-
-